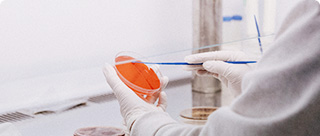

实验室设计规划
实验室设计规划是实验室建设的核心环节,科学合理的设计规划直接影响实验室的功能性、安全性和运行效率。专业的实验室设计需要综合考虑实验流程、空间布局、环境控制、安全防护等多个方面。
秦丹实验室咨询拥有资深的设计团队和丰富的项目经验,为各类实验室提供专业的设计规划服务。我们的设计涵盖化学实验室、生物实验室、物理实验室、检测实验室等多种类型,确保每个项目都能满足相关标准和客户需求。
设计范围:
- 总体规划设计
- 功能分区设计
- 工艺流程设计
- 环境控制系统设计
- 安全防护系统设计
- 配套设施设计
实验室设计规划范围及标准
1. 实验室设计规划范围:
总体布局规划、功能分区设计、工艺流程设计、环境控制设计、安全防护设计、配套设施设计、未来扩展规划等。
2. 实验室设计标准规范:实验室设计规划内容
秦丹实验室为您提供专业、全面的实验室设计规划服务,确保您的实验室设计科学合理、功能完善。
1、总体规划设计
根据实验室功能需求和场地条件,进行总体布局规划和空间配置。
2、功能分区设计
根据实验类型和工作流程,合理划分功能区域,确保各区域功能明确、相互协调。
3、工艺流程设计
包括但不限于以下流程的设计:
--样品接收和预处理流程;
--检测分析流程设计;
--数据处理和报告流程;
--质量控制流程设计;
--废物处理流程设计
等等...
4、环境控制系统设计
根据实验室环境要求,设计以下控制系统:
-通风换气系统设计;
-温湿度控制系统;
-洁净度控制系统;
-噪声控制设计;
-照明系统设计;
-防振动设计;
-电磁屏蔽设计;
-气体供应系统;
-纯水系统设计;
-废气处理系统;
-废水处理系统;
-环境监控系统。
5、安全防护系统设计
• 根据实验室安全要求,设计完善的安全防护系统,包括消防、防爆、防毒等。
• 设计应急疏散通道和安全出口,确保人员安全。
• 配置安全监控和报警系统,实时监控实验室安全状态。
• 设计化学品储存和管理系统,确保危险品安全储存。
• 其他专项安全设计根据实验室特殊需求配置
6、配套设施设计
• 设计完善的供电系统,包括正常供电、应急供电和UPS系统。
• 设计给排水系统,满足实验和生活用水需求。
7、智能化系统设计
现代实验室智能化系统设计包括:
一实验室信息管理系统(LIMS);
一设备管理和监控系统;
一环境监控和控制系统;
一安全监控和门禁系统。
实验室设计规划依据的标准规范
秦丹实验室为您提供专业、全面的实验室设计规划服务,严格按照国家和行业标准执行
- 《实验室建设技术规范》(GB/T27025-2019)
- 《临床实验室设计总则》(GB/T20469-2006)
- 《生物安全实验室建筑技术规范》(GB50346-2011)
- 《通风及空调工程设计规范》(GB50019-2015)
- 《实验室生物安全通用要求》(GB19489-2008)
- 《采暖通风与空气调节设计规范》(GB50019-2003)
- 《洁净厂房设计规范》(GB50073-2013)
- 《建筑给水排水设计规范》(GB50015-2019)
- 《建筑设计防火规范》(GB50016-2014)(2018年版)
- 《低压配电设计规范》(GB50054-2011)
- 《实验室电气安全规范》(GB4793.1-2007)
- 《建筑照明设计标准》(GB50034-2013)
- 《民用建筑工程室内环境污染控制标准》(GB50325-2020)
- 《建筑地面设计规范》(GB50037-2013)
- 《工业建筑防腐蚀设计标准》(GB/T50046-2018)
实验室设计规划能帮您解决的问题
功能布局方面
- • 解决实验室功能分区不合理,影响工作效率的问题;
- • 解决空间利用不充分,布局不科学的问题;
- • 解决工艺流程设计不当,操作不便的问题
环境控制方面
- • 解决通风系统设计不当,环境质量差的问题;
- • 解决温湿度控制不稳定,影响实验结果的问题;
- • 解决洁净度不达标,污染风险高的问题
安全防护方面
- • 解决安全防护设计不完善,存在安全隐患的问题;
- • 解决应急疏散设计不合理,应急响应能力差的问题;
- • 解决危险品储存设计不当,安全风险高的问题;
服务流程
秦丹实验室为您提供专业、全面的实验室设计规划服务,助力您的实验室建设项目成功实施。
STEP 1
需求调研
实验室功能需求分析、场地条件调研、技术要求确定
STEP 2
方案设计
总体规划设计、功能分区设计、系统方案设计
STEP 3
深化设计
详细设计图纸、技术规格书、工程量清单
STEP 4
设计评审
专家评审、方案优化、设计文件完善
STEP 5
施工指导
施工技术交底、现场技术支持、竣工验收
汇策集团旗下的秦丹是专注实验室投资规划、设计施工、仪器配置、运营管理、实验室认证/认可等实验室整体解决方案的专业服务提供商。在实验室认证认可咨询服务、实验室建设和实验室技术服务等领域积累了丰富的专业知识和技术经验,为客户提供全方位的实验室整体解决方案。
秦丹实验室成立于2017年,总部位于广州,陆续在上海、深圳、芜湖等地设立5个全资子公司。为满足全国客户的个性化需求,公司在基础平台层、销售端和交付端持续投入,已逐步构建了较为完善的立体式服务网络和平台,在平台和服务网络紧密合作下,秦丹实验室能高效和迅速地调动各方面的资源,为全国客户提供高质量的实验室认证认可技术服务。
5个全资子公司,多家分支机构
广州海沣检测技术有限公司
上海德垲检测技术有限公司
深圳德恺检测技术有限公司
深圳晟安检测技术有限公司
芜湖秦丹检测技术有限公司
热门问题
实验室设计规划需要考虑哪些主要因素?
实验室设计规划需要考虑以下主要因素:1)功能需求,明确实验室的用途、检测项目、工作流程等基本要求;2)空间条件,包括建筑面积、层高、结构形式等物理条件;3)环境要求,如温湿度、洁净度、通风、照明等环境控制要求;4)安全要求,包括消防、防爆、防毒、防辐射等安全防护要求;5)人员配置,根据工作人员数量和工作方式确定空间需求;6)设备配置,根据仪器设备的类型、数量、安装要求进行空间规划;7)法规标准,严格按照国家和行业相关标准规范进行设计;8)投资预算,在满足功能要求的前提下控制建设成本;9)未来发展,考虑实验室未来扩展和升级的可能性。综合考虑这些因素,才能制定出科学合理的设计方案。
实验室功能分区应该如何设计?
实验室功能分区设计应遵循以下原则:1)流程合理,按照样品处理的工艺流程进行分区,避免交叉污染;2)洁净分级,根据洁净度要求进行分区,从低洁净区到高洁净区逐级过渡;3)安全隔离,将有安全风险的区域与其他区域隔离,如化学试剂储存区、废物处理区等;4)功能集中,将功能相近的区域集中布置,提高工作效率;5)人流物流分离,设计独立的人员通道和物品通道;6)辅助配套,合理配置办公区、休息区、更衣区等辅助功能区域。常见的功能分区包括:样品接收区、样品预处理区、检测分析区、数据处理区、试剂储存区、废物处理区、办公区、会议室、更衣室、休息区等。通过科学的功能分区,可以提高实验室的工作效率和安全性。
实验室通风系统如何设计?
实验室通风系统设计需要考虑以下几个方面:1)通风量计算,根据实验室面积、人员数量、设备散热、有害气体产生量等因素计算所需通风量;2)气流组织,设计合理的送风和排风布局,确保气流从清洁区域流向污染区域;3)压力梯度,通过控制不同区域的压力差,防止有害气体扩散;4)通风柜配置,根据实验需求配置足够数量和合适类型的通风柜;5)排风处理,对含有有害物质的排风进行净化处理后排放;6)应急通风,设计应急排风系统,在紧急情况下快速排除有害气体;7)节能设计,采用变频控制、热回收等技术降低能耗;8)监控系统,安装风速监测、压差监测等设备,实时监控通风系统运行状态。通风系统的设计直接影响到实验室的安全性和舒适性,必须由专业人员进行设计和施工。
实验室安全防护系统包括哪些内容?
实验室安全防护系统包括以下主要内容:1)消防系统,包括火灾自动报警系统、自动喷水灭火系统、气体灭火系统等;2)防爆系统,对于有爆炸危险的区域,采用防爆电气设备、防爆通风设备等;3)防毒系统,包括有毒气体检测报警、应急通风、个人防护设备等;4)防辐射系统,对于涉及放射性物质的实验室,设置辐射防护屏蔽、监测设备等;5)应急救援系统,包括紧急洗眼器、冲淋设备、急救箱、应急药品等;6)安全监控系统,包括视频监控、门禁控制、入侵报警等;7)应急疏散系统,设计合理的疏散通道、应急照明、疏散指示标志等;8)环境监测系统,监测实验室内的温度、湿度、气体浓度等环境参数;9)废物处理系统,安全处理实验产生的危险废物。完善的安全防护系统是实验室安全运行的重要保障。
如何选择专业的实验室设计公司?
选择专业的实验室设计公司应考虑以下几个方面:1)资质能力,选择具有相应设计资质和丰富经验的专业公司;2)技术团队,了解设计团队的专业背景和项目经验,确保具备相关领域的专业知识;3)成功案例,查看公司以往的设计案例,特别是与自己项目类似的案例;4)设计理念,了解公司的设计理念和技术路线,确保与项目需求匹配;5)服务范围,选择能够提供从设计到施工指导全过程服务的公司;6)技术创新,了解公司在新技术、新材料应用方面的能力;7)质量保证,了解公司的质量管理体系和质量保证措施;8)客户评价,通过客户反馈了解公司的服务质量和信誉;9)价格合理,在保证质量的前提下选择价格合理的公司。秦丹实验室咨询作为专业的实验室设计咨询机构,拥有资深的设计团队和丰富的项目经验,能够为客户提供高质量的设计服务。